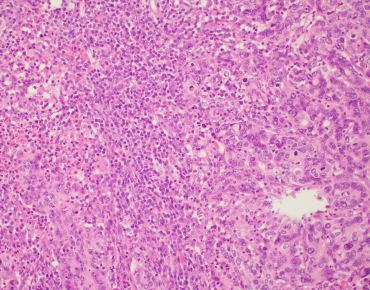
Image

- Tutorial Videos
- Learn to score TILs in invasive breast cancer
- Learn to score TILs in solid tumors and in the metastatic setting
- Learn to score TILs in residual disease after treatment
- Learn to score TILs in DCIS
- Want more reference images and pitfall exercises? Click here!
Self Training: TILs Scoring
Having trouble viewing the video? Try: https://www.youtube.com/watch?v=qkrXf50fBqE&t=35s
Self Training: Updated TIL-training video
Having trouble viewing the video? Try: https://www.youtube.com/watch?v=wcIHZWFa4eI
TILs assessment in metastatic tumor deposits
TILs assessment in endometrial carcinoma tutorial.
TILs assessment in melanoma tutorial
TILs assessment in lung adenocarcinoma tutorial
TILS assessment in mesothelioma tutorial
TILS assessment in endometrial carcinoma tutorial
TILs assessment in ovarian carcinoma tutorial
TILs assessment in urothelial carcinoma tutorial
TILs assessment in colorectal carcinoma tutorial